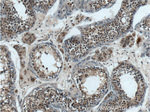
TPRX1 Antibody in Immunohistochemistry (Paraffin) (IHC (P))

Search
Proteintech
TPRX1 Polyclonal Antibody
{{$productOrderCtrl.translations['antibody.pdp.commerceCard.promotion.promotions']}}
{{$productOrderCtrl.translations['antibody.pdp.commerceCard.promotion.viewpromo']}}
{{$productOrderCtrl.translations['antibody.pdp.commerceCard.promotion.promocode']}}: {{promo.promoCode}} {{promo.promoTitle}} {{promo.promoDescription}}. {{$productOrderCtrl.translations['antibody.pdp.commerceCard.promotion.learnmore']}}

Please note: We are reviewing Western blot images included in the antibody testing data in our catalog, including those provided by third parties. Unless expressly labeled or annotated as “raw-unedited”, Western blot images included in the antibody testing data in our catalog may have been edited, optimized or otherwise adjusted for presentation.
产品信息
25834-1-AP
种属反应
宿主/亚型
分类
类型
抗原
偶联物
形式
浓度
规格
纯化类型
保存液
内含物
保存条件
运输条件
产品详细信息
Immunogen sequence: PGCRAQKGI PAALSPGPGP IPAPIPGPAQ IPGPLPGSIP GPIPGPAQIP SPIPAPIPGP ISGPVQIPGP FRGPIPGPIS GPAPIPGPIS GPFSGPNPGP IPGPNPGPIP GPISGPIPGP ISVPIPGPIP GPISGPISGP NPGPIPGPIP GPISGPNPGP IPGPISGPNP GLIPGPIPGP ISGPGPIIGP IPSPAQIPGP GRLQGPGPIL SPGRMRSPGS LPGLAPILGP GSGPGSGSVP APIPGPGSLP APAPLWPQSP DASDFLPDTQ LFPHFTELLL PLDPLEGSSV STMTSQYQEG DDSMGKKHSG SQPQEEGGSV NENHSGPRLL LDL (80-411 aa encoded by BC137501)
靶标信息
Homeobox genes encode DNA-binding proteins, many of which are thought to be involved in early embryonic development. Homeobox genes encode a DNA-binding domain of 60 to 63 amino acids referred to as the homeodomain. This gene is a member of the TPRX homeobox gene family.
仅用于科研。不用于诊断过程。未经明确授权不得转售。




